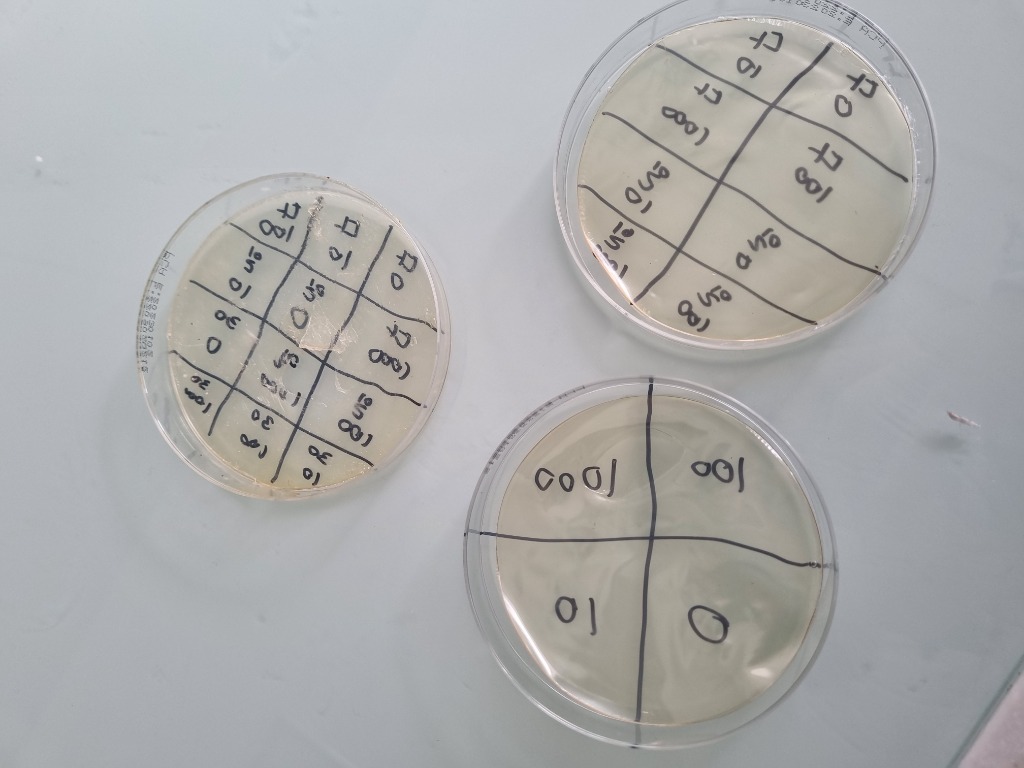
배지 배양 결과 사진

이론적 배경
항생제: 미생물에 의하여 만들어진 물질로서, 다른 미생물의 성장과 증식을 억제하고 사멸시키는 물질을 말한다.
아목시실린: 항생제의 한 종류로, 세균의 세포벽 합성을 억제하는 형식으로 작용한다. 페니실린과 같은 베타-락탐계 항생제이다.
항생제 내성균: 특정 항생제에 대한 저항하는 방법을 만들어 해당 약물의 효과가 작용하지 않는 세균이다.
항생제: 미생물에 의하여 만들어진 물질로서, 다른 미생물의 성장과 증식을 억제하고 사멸시키는 물질을 말한다.
아목시실린: 항생제의 한 종류로, 세균의 세포벽 합성을 억제하는 형식으로 작용한다. 페니실린과 같은 베타-락탐계 항생제이다.
항생제 내성균: 특정 항생제에 대한 저항하는 방법을 만들어 해당 약물의 효과가 작용하지 않는 세균이다.
항생제가 토양 미생물 환경 및 식물의 성장에 미치는 영향을 확인하여 항생제의 토양 축적이 환경 생태계에 미칠 수 있는 영향을 탐구한다.
아목시실린을 녹인 물을 농도별로 준비하여 1달간 지속적으로 관수하고, 식물의 성장 정도와 해당 토양에 대한 배지 배양 결과를 기록하는 실험을 진행한다.
0mg/L, 10mg/L, 100mg/L, 1000mg/L의 농도에 맞게 200ml의 물에 대해 아목시실린을 녹여 관수용 물을 준비한 후, 재배용 키트에 씨앗을 파종한다.
1달간 주기적으로 관수로 하여 성장 과정을 사진으로 기록하고, 이후 식물의 뿌리 길이, 줄기 길이, 생체중을 측정하여 기록한다.
실험이 종료된 후 증류수를 이용하여 토양을 10,000배 희석하고, 희석된 액체 시료를 고체 LB 배지와 아목시실린을 섞은 배지에 도말하여 섭씨 37도의 온도에 48시간 동안 배양한다. 배양이 끝나면 집락의 수나 면적 등을 비교해 결과를 기록한다.
1차 실험 결과 아목시실린의 농도가 높아질수록 식물의 뿌리가 길어지는 현상이 나타났다. 이는 환경 스트레스 회피성 신장으로 분석되며, 독성 물질을 피하기 위해 뿌리를 깊게 늘렸을 가능성을 시사한다.
또한 고농도의 항생제 환경에서 줄기 길이가 뚜렷히 감소하는 현상을 보였는데, 이는 고농도 항생제로 인한 스트레스 때문에 성장에 사용할 에너지를 해독 및 방어 위주로 사용하여 생긴 현상으로 분석할 수 있다.
100mg/L의 중간 농도 항생제 농도에서 평균 생체중이 가장 높은 현상이 생겼는데, 이는 약한 스트레스로 인해 식물이 방어를 위해 성장을 촉진한 결과로 해석된다. 이는 단기적으로는 성장에 도움이 되어 보이지만, 장기적으로는 에너지 소모 혹은 노화 촉진 등 식물에게 부정적 영향을 끼칠 수 있다.

사진1. 1차 실험 사진
| 대상 | 0mg/L | 10mg/L | 100mg/L | 1000mg/L |
|---|---|---|---|---|
| 뿌리 길이 | 2.16cm | 2.97cm | 3.4cm | 4.9cm |
| 줄기 길이 | 17.3cm | 16.6cm | 18.4cm | 14.16cm |
| 생체중 | 0.266g | 0.264g | 0.301g | 0.277g |
표1. 항생제 농도에 따른 개체군 별 측정 결과의 평균
2차 실험은 1차 실험의 문제점이었던 웃자람 현상을 보호하기 위해 야외 노출 시간을 늘려 줄기가 두껍게 자라는 경향을 보였지만, 온도와 수분 조절 실패 문제로 식물이 모두
죽어버려 통계 결과를 낼 수 없었다.
비록 2차 실험에서 식물 성장으로는 유의미한 결과를 내지 못했지만, 더 정확한 비교를 위해 시중 멸균 흙과 동시에 사용한 학교 뒤뜰의 일반 흙에 대한 배지 배양을 함께
진행했다.

사진 2. 2차 실험 사진
배지 배양 결과 고체 배지가 건조되는 문제가 발생했다. 이를 고체 배지가 얇았거나, 액체 시료 도달 과정에서 문제가 생겨 발생한 것으로 분석했다. 이로 인해 아목시실린을 섞었던 배지는 찢어지고 기포가 생겨 결과 분석을 할 수 없었지만, 일반적인 고체배지에서 나타난 정상 구조를 토대로 결과를 분석했다.
0mg/L, 10mg/L의 저농도 항생제 환경에서 일반 흙이 멸균 흙보다 정상 구조가 많이 나타났다. 이는 시중에서 판매하는 멸균 흙보다 일반 흙에 더 많은 종류의 미생물이 살기 때문에 배지 배양이 잘못되지 않았을 가능성을 보여준다.
반면, 100mg/L와 1000mg/L의 항생제 환경에서는 일반 흙에서는 정상 구조가 드러나지 않았지만, 멸균 흙에서는 저농도 환경과 유사한 개수와 면적의 정상 구조가 나타났다. 이는 항균 처리가 된 멸균 흙에 내성균이 존재할 가능성을 시사한다.
사진 3. 배지 배양 결과 사진
이번 실험은 항생제인 아목시실린의 토양 노출이 식물의 성장과 토양 미생물 환경에 미칠 수 있는 영향을 확인하고자 진행되었다. 실험 결과 아목시실린이 토양의 미생물 환경 변화와 화학적 스트레스로 인한 식물의 생리적 반응의 간접적 영향을 주어 환경에 영향을 미칠 수 있음을 확인할 수 있었다.
즉, 항생제는 단순히 병원균에만 영향을 미치는 것이 아니며, 지구 환경으로 유출되었을 때 다양한 생명체와 전체적인 생태계에 복합적인 영향을 미칠 수 있다고 결론지었다.